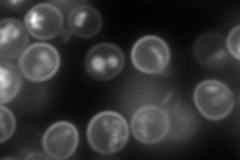
YCR098C

View description
Plasma membrane permease, mediates uptake of glycerophosphoinositol and glycerophosphocholine as sources of the nutrients inositol and phosphate; expression and transport rate are regulated by phosphate and inositol availability
Localization:
Intensity:
Fold change:
Significance:
-
C’ GFP library in SD

below threshold15.58 -
N' NOP1pr-GFP in SD

cell periphery,vacuole137.536 -
N' TEF2pr-mCherry in SD
cell periphery,vacuole251.373 -
N' NATIVEpr-GFP in SD

below threshold18.1416 -
N' TEF2pr-VC and Cyto-VN in SD

cell periphery,punctate46.6305 -
C’ GFP library in SD+DTT

cytosol14.180.9No -
C’ GFP library in SD+H2O2

cytosol15.611No -
C’ GFP library in Starvation Media

cytosol17.481.12No -
C’ GFP library on the background of Pup2-DaMP

below threshold -
C’ GFP library on the background of CCT mutant

below threshold15.0040.962174No
